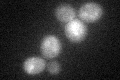

View description
O-mannosylated heat shock protein that is secreted and covalently attached to the cell wall via beta-1,3-glucan and disulfide bridges; required for cell wall stability; induced by heat shock, oxidative stress, and nitrogen limitation
Localization:
Intensity:
Fold change:
Significance:
-
C’ GFP library in SD

below threshold16.48 -
N' NOP1pr-GFP in SD

cell periphery,vacuole40.9866 -
N' TEF2pr-mCherry in SD

cell periphery,vacuole16.5335 -
N' NATIVEpr-GFP in SD

cytosol413.372 -
N' TEF2pr-VC and Cyto-VN in SD

#N/A0 -
C’ GFP library in SD+DTT
cytosol16.380.99No -
C’ GFP library in SD+H2O2

cytosol17.431.05No -
C’ GFP library in Starvation Media

cytosol15.490.93No -
C’ GFP library on the background of Pup2-DaMP

below threshold -
C’ GFP library on the background of CCT mutant

below threshold18.34621.11265No
